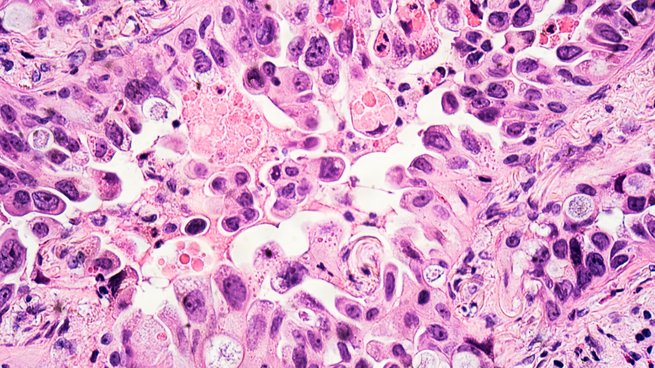
Krebsgewebe

Biobanken - die Schatzkammern der Medizin
Biobanken lagern weder Geld noch Gold, sondern Blut, Gewebe oder Körperflüssigkeiten von Menschen. Sie sind innovative Speicher für Proben und Daten, ohne die moderne Forschung nicht möglich wäre. Bei bestimmten Krankheiten helfen Biobanken dabei, diese besser zu behandeln. Einige Lungenkrebsarten gehören dazu. Die Bildgeschichte zeigt ein Beispiel, wie die Präzisionsmedizin beim nicht-kleinzelligen Lungenkarzinom zum Einsatz kommt.

Mit ihrer Probenspende hat Karin einen wichtigen Beitrag für den Fortschritt der Medizin geleistet.




